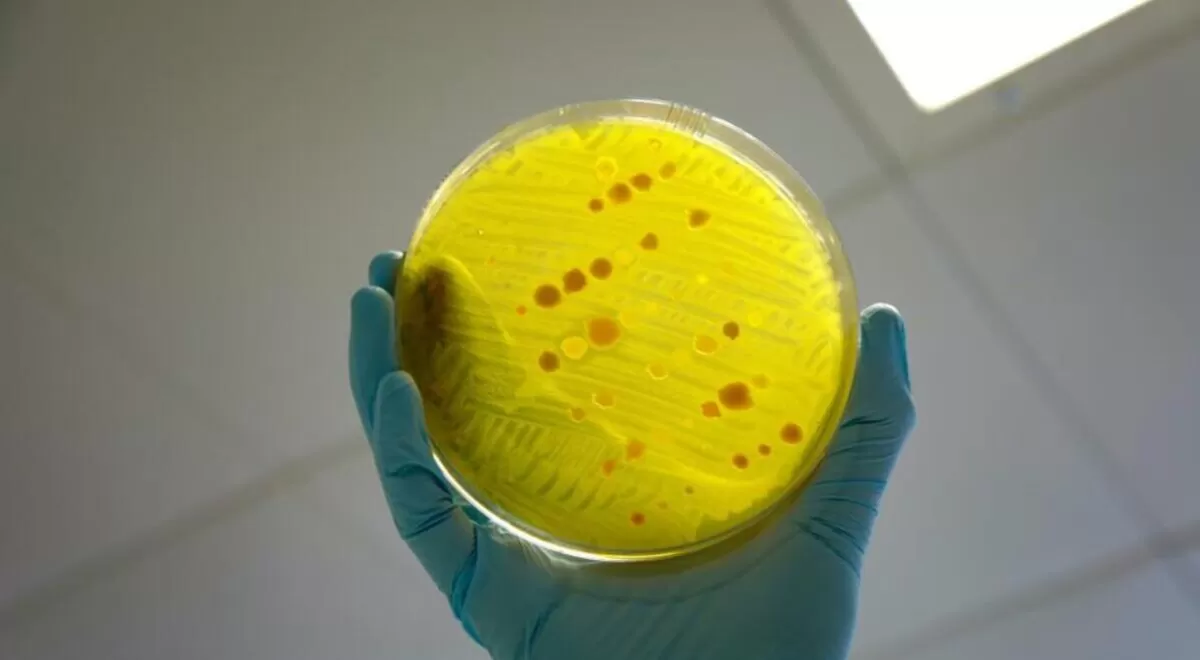

Las aguas residuales hospitalarias, foco emergente en la propagación de la resistencia antimicrobiana
- 1379 lecturas
La resistencia a los antimicrobianos (RAM) continúa consolidándose como una de las principales amenazas para la salud pública mundial. En la Unión Europea, se asocia a más de 35.000 muertes anuales, y desde 2017 forma parte de una estrategia prioritaria bajo el enfoque One Health, que integra la salud humana, animal y ambiental.
Un nuevo estudio publicado en Ecotoxicology and Environmental Safety analiza el papel de las aguas residuales hospitalarias en la diseminación de la RAM, un aspecto hasta ahora poco explorado. La investigación, liderada por científicos que utilizaron como caso de estudio Noruega —país con bajo consumo de antibióticos y baja prevalencia de RAM—, revela que incluso en contextos de baja resistencia clínica existe una elevada diversidad de genes de resistencia en los efluentes hospitalarios.
Más de 1.100 genes de resistencia identificados
Los investigadores recogieron muestras durante 24 horas en tres puntos: aguas residuales hospitalarias sin tratar, influente de la planta de tratamiento Holen (que recibe vertidos de dos hospitales) y efluente tratado.
En total, se detectaron 28 familias bacterianas, incluyendo cepas resistentes de Escherichia coli y Klebsiella spp., presentes tanto antes como después del tratamiento.
El análisis genético identificó 1.130 genes de resistencia a antibióticos (ARG), de los cuales 349 eran nuevos y previamente desconocidos, surgidos por procesos evolutivos. Entre ellos se encontraban genes asociados a la resistencia a carbapenémicos, antibióticos de último recurso empleados frente a infecciones multirresistentes.
Persistencia tras el tratamiento
El estudio detectó 40 ARG comunes en aguas residuales hospitalarias sin tratar, en el influente de planta y en el efluente tratado. Además, se identificaron 14 ARG adicionales compartidos únicamente entre el efluente hospitalario y el tratado, lo que sugiere que ciertos genes introducidos por los hospitales persisten incluso tras el tratamiento convencional.
Estos resultados indican que los efluentes hospitalarios pueden actuar como fuente significativa de diseminación de genes de resistencia hacia el medio receptor, incluso en países con una carga relativamente baja de RAM.
Implicaciones para la gestión del agua y la normativa europea
La investigación cobra especial relevancia tras la actualización en 2024 de la Directiva europea sobre tratamiento de aguas residuales urbanas, que incorpora la obligación de monitorizar la RAM en aguas residuales para mejorar el conocimiento y fundamentar políticas públicas.
El enfoque metodológico aplicado —basado en técnicas genéticas de alta resolución— podría servir de modelo para otros países en el seguimiento ambiental de la RAM.
Entre las posibles estrategias de mitigación, los autores apuntan al tratamiento in situ de efluentes hospitalarios o a tecnologías específicas para eliminar bacterias portadoras de genes de resistencia antes de su vertido a redes generales.
Un desafío creciente bajo el enfoque One Health
En 2025, la UE puso en marcha la Asociación Europea One Health contra la RAM (OHAMR), cofinanciada por Horizonte Europa, con el objetivo de reforzar la investigación y la innovación frente a esta amenaza.
El estudio subraya que la lucha contra la RAM no puede limitarse al ámbito clínico y farmacéutico, sino que requiere integrar la dimensión ambiental, especialmente la gestión de las aguas residuales, como parte esencial de las estrategias de prevención.
Referencia:
Victor, MP et al. (2025). Hospital effluents in low-resistance settings are responsible for dissemination of novel antibiotic resistance genes into the marine environment. Ecotoxicology and Environmental Safety, 301, 118390.

















